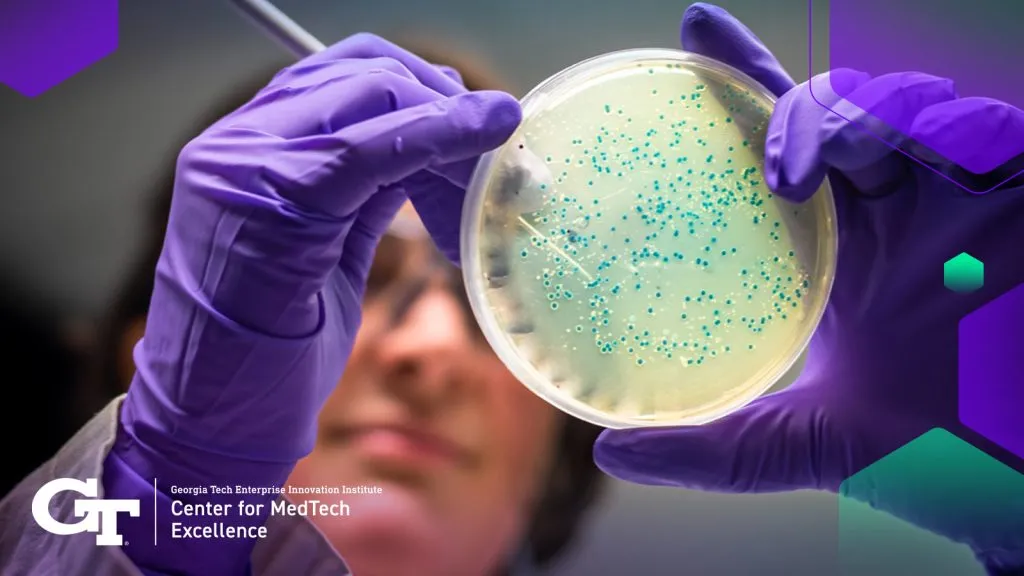
researcher looking at micro-organisms in a petri dish

The human body is host to a diverse and complex ecosystem of microorganisms, collectively known as the microbiome. These microorganisms, including bacteria, viruses, fungi, and archaea, inhabit various parts of the body, such as the gut, skin, mouth, and reproductive organs. Over the past few decades, advancements in microbiome research have revealed the significant role that these microscopic inhabitants play in human health and disease. As our understanding of the microbiome deepens, so does the need for sophisticated analytical tools that enable comprehensive exploration, diagnosis, and treatment interventions. In this article, we delve into the world of microbiome analytical tools, highlighting their applications in research, clinical prevention, and treatments.
Microbiome Research and Analysis
Microbiome research involves the study of microbial communities residing within and on the human body. This field has undergone a revolution due to the development of high-throughput sequencing technologies. These tools allow scientists to analyze the genetic material of microorganisms present in a given sample. The primary technology employed for microbiome analysis is 16S rRNA gene sequencing and metagenomic shotgun sequencing.
16S rRNA gene sequencing involves sequencing a specific region of the bacterial 16S ribosomal RNA gene. This approach provides information about the composition and diversity of bacterial communities present in a sample. By comparing sequences to existing databases, researchers can identify different bacterial taxa and study their abundance and relationships.
Metagenomic shotgun sequencing goes a step further by sequencing all genetic material present in a sample, including bacteria, viruses, and other organisms. This method provides a more comprehensive view of the microbiome’s functional potential, allowing scientists to identify specific genes and metabolic pathways.
Advanced data analysis tools, such as bioinformatics pipelines and machine learning algorithms, help process and interpret the vast amount of sequence data generated. These tools enable researchers to identify specific microbial functions, predict disease risk, and uncover potential therapeutic targets.
Clinical Applications and Prevention
Microbiome research has yielded insights that extend beyond the laboratory and into clinical practice. Understanding the role of the microbiome in health and disease has opened new avenues for disease prevention, diagnosis, and treatment.
Disease Diagnosis and Risk Assessment: Microbiome analysis can aid in diagnosing various diseases and assessing disease risk. Altered microbiome compositions have been linked to conditions such as inflammatory bowel disease (IBD), obesity, diabetes, and even mental health disorders. By comparing the microbiomes of healthy individuals to those with certain diseases, clinicians can identify potential biomarkers for early disease detection.
Personalized Medicine: The concept of personalized medicine has gained traction with microbiome research. By analyzing an individual’s microbiome, clinicians can tailor treatment strategies to the unique microbial composition of each patient. This approach has shown promise in areas such as cancer treatment, where the microbiome can influence the efficacy and side effects of chemotherapy.
Preventive Interventions: Understanding the microbiome’s role in health has led to the development of preventive interventions. For example, probiotics—live microorganisms that confer health benefits—can be administered to restore a healthy microbial balance. Additionally, dietary modifications aimed at promoting the growth of beneficial bacteria and limiting harmful ones are being explored as preventive measures.
Microbiome-Based Therapies
Microbiome research has paved the way for innovative therapeutic strategies that harness the power of microbial communities to treat various diseases.
Fecal Microbiota Transplantation (FMT): FMT involves transferring fecal material from a healthy donor to a patient’s gut in order to restore a balanced microbial community. This approach has been remarkably effective in treating recurrent Clostridium difficile infections and is being investigated for other conditions like inflammatory bowel disease and irritable bowel syndrome.
Synthetic Microbiota: Researchers are exploring the concept of creating synthetic microbial communities that can be introduced into a patient’s body to restore or enhance health. These engineered microbiotas could be designed to produce specific therapeutic molecules, modulate immune responses, or outcompete harmful pathogens.
Microbiome-Targeted Drugs: The microbiome’s influence on drug metabolism has prompted the development of drugs that interact with microbial communities. Certain medications can alter the composition of the gut microbiome, impacting drug effectiveness and side effects. Designing drugs with the microbiome in mind could lead to more personalized and efficient treatments.
Challenges and Future Directions
While microbiome analytical tools have revolutionized our understanding of human health, several challenges remain. The complexity of microbiome data, the lack of standardized protocols, and the need for longitudinal studies are ongoing concerns.
Future developments in microbiome research are likely to focus on improving our understanding of microbial interactions, elucidating the role of the virome (viruses in the microbiome), and refining the link between the microbiome and immune system. As the field advances, microbiome-based therapies could become an integral part of medical practice, leading to more targeted and effective treatments for a wide range of diseases.
In conclusion, microbiome analytical tools have transformed our understanding of human health and disease. From fundamental research to clinical applications and novel therapies, these tools are enabling scientists and clinicians to unlock the potential of the microbiome. As technology continues to evolve, the microbiome’s intricate role in our well-being will be further unraveled, paving the way for a new era of personalized medicine and innovative treatments.